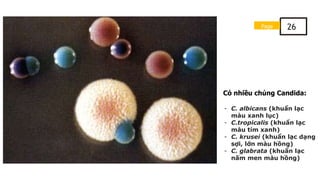
Có nhiều chủng Candida:
- C. albicans (khuẩn lạc
màu xanh lục)
- C.tropicalis (khuẩn lạc
màu tím xanh)
- C. krusei (khuẩn lạc dạng
sợi, lớn màu hồng)
- C. glabrata (khuẩn lạc
nấm men màu hồng)
Page 26

Sổ tay bệnh do nấm Candida cung cấp cái nhìn tổng quan về candidiasis, một bệnh nhiễm trùng gây ra bởi nấm Candida, chủ yếu là C. albicans, với nhiều triệu chứng và cách điều trị khác nhau. Nấm Candida có thể lây lan qua tiếp xúc trực tiếp hoặc gián tiếp và thường gây ra các vấn đề ở vùng sinh dục, hầu họng, da và móng. Tài liệu cũng nhấn mạnh tầm quan trọng của việc thăm khám và điều trị kịp thời để tránh biến chứng.